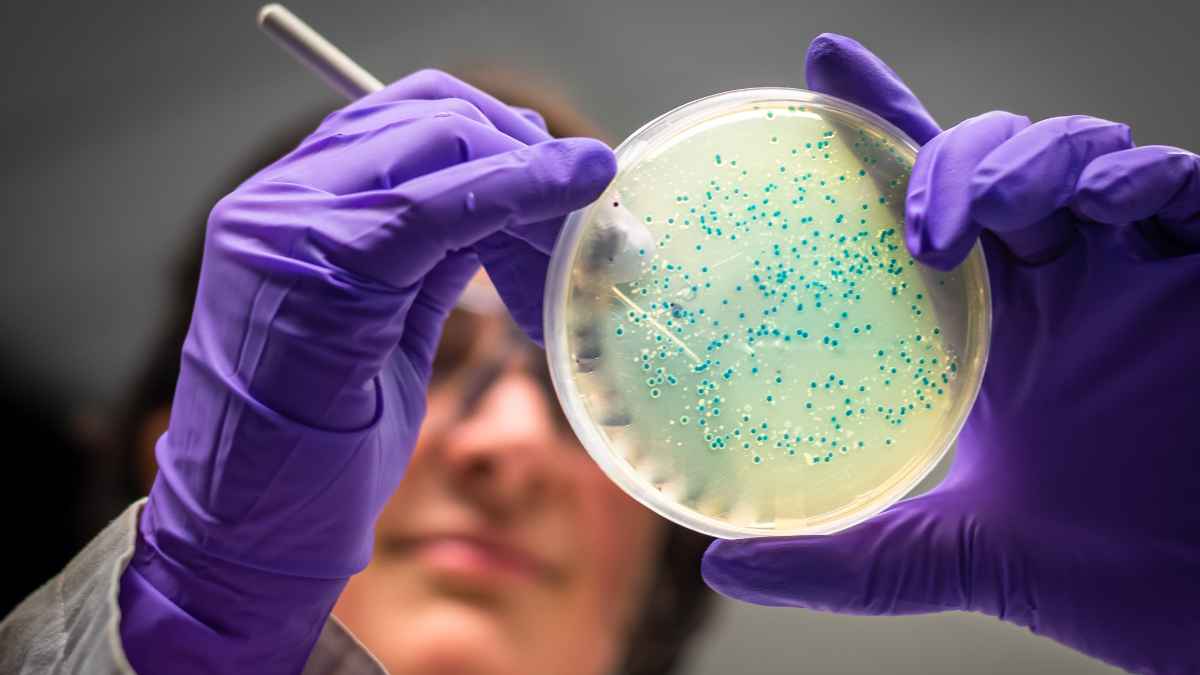
Gut microbiota testing

IDEAYA Biosciences Inducement Grants to New Employees
IDEAYA Biosciences, Inc. has announced new IDEAYA Biosciences inducement grants under Nasdaq Listing Rule 5635(c)(4). The grants were approved on February 26, 2026, by the Compensation Committee of the company’s Board of Directors.
The precision oncology company awarded non-qualified stock options to purchase an aggregate of 346,200 shares of its common stock to three newly hired employees. Importantly, these equity awards were granted as inducement material for entering into employment with IDEAYA. Therefore, the grants comply with Nasdaq Listing Rule 5635(c)(4), which permits such awards outside of shareholder-approved equity plans.
Details of the 2023 Inducement Plan
The awards were granted under the IDEAYA Biosciences, Inc. 2023 Employment Inducement Incentive Award Plan. This plan is used exclusively for individuals who were not previously employed by IDEAYA or who are rejoining after a bona fide period of non-employment. As a result, the company ensures that inducement awards align with regulatory requirements.
The stock options carry an exercise price of $31.90 per share. Notably, this price matches the closing price of IDEAYA’s common stock on The Nasdaq Global Select Market on the grant date. The options have a 10-year term, which provides long-term incentive alignment with company performance.
Vesting Structure and Employment Conditions
The IDEAYA Biosciences inducement grants follow a four-year vesting schedule. Specifically, 25% of the options vest on the first anniversary of the vesting commencement date. Subsequently, the remaining 75% vest in equal monthly installments over the next three years.
However, vesting remains subject to the employee’s continued service with the company on each applicable vesting date. Consequently, this structure promotes retention while aligning employee incentives with long-term shareholder value.
Overall, these inducement grants reflect IDEAYA’s ongoing commitment to attracting top talent in precision oncology. At the same time, the company maintains compliance with Nasdaq regulations while supporting its strategic growth objectives.
Read Also: Avanos Board Nominees Include Jim Cunniff and Bill Burke for 2026 Election